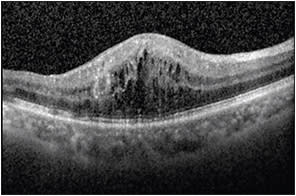

Appropriate Interpretation of OCT Imaging
A review with a protocol for accurate reading
GHAZALA DATOO O’KEEFE, MD • SRINIVAS R. SADDA, MD
The advent of optical coherence tomography has revolutionized imaging in ophthalmology since its introduction two decades ago. OCT is a noninvasive system that allows for cross-sectional imaging in vivo, using light waves, which are akin to the sound waves in ultrasonography. The purpose of this article is to discuss the interpretations and limitations of OCT imaging.
A HISTORY OF OCT
The initial application of low-coherence interferometry in ophthalmology was for measurements of axial length.1 Low-coherence interferometry was then adapted for use in OCT.
The first scanning system used a moving reference mirror to capture distance and morphologic information about various intraocular structures, based on a time delay. The reflected light from the sample and the reference arms of the OCT create constructive and destructive patterns that are picked up by the detector, forming interferograms. These interferograms are subsequently used to create an image of a retinal section or, if multiple point were scanned, a B-scan.2
Time-domain OCT was limited by the movement of the reference mirror, and the early systems had a scanning speed of approximately 400 axial scans/second, with a resolution of 10 µm. The integration of broadband light sources into OCT and the use of a spectrometer, instead of a moving reference mirror, have allowed for faster image acquisition, greater sensitivity, and higher resolution up to 2 µm, when combined with adaptive optics approaches.
Ghazala Datoo O’Keefe, MD, and SriniVas R. Sadda, MD, serve on the faculty of the UCLA-Doheny Eye Center of the University of California-Los Angeles. Neither author reports any financial interests in products mentioned in this article. Dr. O’Keefe can be reached via e-mail at O’keefe@jsei.ucla.edu.
A-scan acquisition speeds have increased to 300,000 axial scans/second and beyond in the latest swept-source (SS-OCT) and full-field (FF-OCT) OCT systems.3 Higher resolution has allowed for better delineation of the different layers of the retina and better visualization of pathologies. Increased sensitivity has improved the signal-to-noise ratio in these devices, allowing for visualization of previously difficult-to-detect interfaces, such as the vitreoretinal interface.
With spectral domain OCT, however, the sensitivity is not constant throughout the image. As the tissue of interest moves further from the point of maximum sensitivity (called the “zero delay line”), the quality of the image can decrease, and more noise can appear. The operator can choose to acquire images such that the vitreous or choroidal side is closer to point of maximal sensitivity.
By default, most devices are set such that the maximal sensitivity is on the vitreous side (top of the scanning window); thus, the user will need to change a setting if the zero delay line is to be switched to the choroidal side.
Therefore, it becomes important to have a sense of what the pathology of the eye is and what part of the scan should have the highest resolution or image quality. For example, in patients with central serous chorioretinopathy, in which evaluation of the choroid and its thickness is important, it is advisable to perform the scan so that the choroid is on the higher part of the display (upside down image), so the choroid is closest to the point of maximal sensitivity.
Many devices now allow the user to flip the point of maximal sensitivity without actually flipping the image on the screen (ie, maintaining a right-side-up image). The faster scanning speeds of spectral-domain OCT, SS-OCT, and FF-OCT allow for increased patient comfort, reduced motion artifacts, denser scanning, and, thus, better intravisit and intervisit registration of images for comparison. Denser scanning also decreases the likelihood of missing small lesions of potential interest between the scanning lines.
BASIC PRINCIPLES IN IMAGE INTERPRETATION
Successful OCT image interpretation depends on multiple factors, the most pertinent of which is a good understanding of retinal histology and histopathology. The image produced by the OCT is a reconstruction of the retina based on light waves, so a thorough understanding of the same is necessary.
Furthermore, being conversant in the standardized terms is important to be able to convey your message to others in your field. As an extension of this concept, it is important to understand what “normal” is, as well as the spectrum of “normal.”
Interpretation of the OCT image requires understanding that the image was based on light waves. Thus, the image is subject to the characteristics of light waves, and one can see reflections, attenuations, interfaces, and shadows in the image due to this property of light.
PROTOCOL FOR READING OCT SCANS
Evaluate More Than Only the Thickness Map
Segmentation errors are less frequent in SD-OCT images than with TD-OCT, but they still occur. Segmentation errors can translate into misinformation on the retinal thickness map, on which many practitioners rely. For example, assessment of a pigment epithelial detachment (PED) on a thickness map depends on appropriate retinal pigment epithelium segmentation lines.
Our recommendation is to view the entire volume scan for each OCT performed. While this procedure is more time consuming than glancing at the thickness map and a single averaged OCT scan, it can prevent diagnostic errors and management errors.
Furthermore, reviewing the adjacent scans can help to elucidate and define ambiguous features on individual B-scans. In a busy clinical environment with multiple OCT machines, it is worth investing in imaging software that allows for the review of volume scans from different modalities. In the case of offices with a single OCT machine, you can view volume scans using the manufacturer-provided reviewing software.
Perform a Systemic Review of the Retinal Layers for Abnormalities
It is important to perform a systematic review of each retinal layer to avoid missing abnormalities. It is useful to evaluate each layer for abnormalities in reflectivity or brightness, thickness, continuity, and surface contour.
An increase in the reflectivity and thickness of only the inner retinal layers can imply cytotoxic edema, which can occur in the setting of acute retinal artery occlusion. Increased areas of brightness within the retina may correspond to lipid exudates or pigment, whereas an increased area of brightness along the surface of the retina likely corresponds to an epiretinal membrane or abnormal vitreomacular interface (Figure 1).

Figure 1. OCT image demonstrating hyper-reflectivity along the surface of the retina corresponding to an epiretinal membrane. Note the associated posterior vitreous detachment.
Increased areas of brightness may cause shadowing immediately below and should not be confused for the presence of fluid or edema. A decreased area of brightness in the retina in a cystic configuration usually corresponds to cystoid macular edema (Figure 2), whereas decreased brightness below the retina but above the RPE implies the presence of subretinal fluid.
Figure 2. OCT image demonstrating hyporeflectivity in the retina in a cystic configuration corresponding to cystoid macular edema.
A PED manifests as decreased brightness below the RPE. Thinning or loss of the inner retinal layers (and not only the nerve fiber and ganglion cell layer) can imply prior disease, such as an ischemic branch retinal vein occlusion or a branch retinal artery occlusion. Loss of the RPE can be indicative of atrophy in patients with age-related macular degeneration.
Discontinuous bands in the peripheral outer retina can imply hydroxychloroquine toxicity or retinitis pigmentosa. Abnormalities in RPE contour can imply the presence of drusen (Figure 3, page 56) or PEDs from CSC.

Figure 3. OCT image demonstrating RPE abnormalities consistent with reticular pseudodrusen.
Consider Confounders Affecting the Interpretation of Brightness and Continuity
OCT is based on reflections of light; thus, bright objects, such as lipid or pigment, can cause a shadowing immediately below them. These lesions may suggest a loss of outer retinal structures at a quick glance.
Similarly, areas of retina that have substantial thickening may result in reduced signal at the outer retinal bands, for example, in massive CME. Averaging of scans is a useful technique to overcome or minimize this problem.
Furthermore, loss of signal can occur with increasing depth in the image. This is one of the reasons that enhanced depth imaging (EDI) approaches, flipping the deeper structures toward the side of maximal sensitivity, are useful.
Consider Whether the Abnormality May Be an Artifact
With SD-OCT, two images are produced: an upright image and a conjugate (upside down) mirror image. With EDI, you are essentially bringing the conjugate image into view.
Because viewing both the upright image and the conjugate image at the same time is not typically useful, most devices clip one of the images out of the viewing window. In some cases, especially in patients with high myopia or those with large retinal detachments, portions of the conjugate image may extend onto the primary image, giving the appearance of an abnormal contour to the retina.
Similarly, in a patient with asteroid hyalosis, the structures in the vitreous may be reflected above, within, and below the retina, whereas in reality, they exist only above the retina in the vitreous cavity.
OCT IN THE MANAGEMENT OF DISEASES
Use of OCT in the Management of Glaucoma
OCT and its use in the measurement of peripapillary retinal nerve fiber layer (RNFL) thickness is a common method for diagnosing and monitoring glaucoma with anatomic parameters. Repeatability of RNFL thickness is high with SD-OCT, and intervisit 95% tolerance limits for average RNFL thickness were found to be approximately 4 µm.4 Progression detection, however, should be monitored on the same device at follow-up visits.4
Ganglion cell analysis of the macula has also been shown to help in the identification of early-onset glaucoma, especially when used in conjunction with RNFL analysis.5 Recent studies have evaluated a combined structural index, based on the peripapillary RNFL, the macular ganglion cell analysis, and the optic disc, compared to individual parameters. These studies have found that the combination of the three was more sensitive in detecting glaucoma and in reducing false negatives by approximately 44%.6
Use of OCT in the Management of AMD
In patients with AMD, OCT is often used to monitor the patient, as well as the need for or response to treatment. OCT is a very useful tool in monitoring the retina in a noninvasive manner.
Evaluation of volume scans is important in identifying features, such as outer retinal tubulations (ORTs) in AMD. ORTs appear as round or ovoid hyper-reflective structures with a central area of hyporeflectivity (Figure 4).

Figure 4. OCT image demonstrating an ovoid hyper-reflective structure with a central area of hyporeflectivity corresponding to an outer retinal tubulation.
This configuration can be confused for intraretinal cysts, and care must be taken to differentiate these structures, especially when management depends on appropriate interpretation.
Up to 2.5% of eyes can have ORTs present at the time of diagnosis of neovascular AMD, and up to 45% of eyes showed development of ORTs by four years.7 ORTs tend to develop adjacent to areas of geographic atrophy or hyper-reflective subretinal tissue, and they appear to be predictive of slower rates of growth of GA when compared with eyes without ORTs.8
It is also important, however, to bear in mind the limitations of this technology. The presence of areas of decreased brightness can correspond to fluid, but this does not necessarily correlate with the presence of neovascular AMD. Areas that appear to be fluid may be chronic cysts secondary to the presence of damaged RPE. In these situations, fluorescein angiography remains the best method to assess for the presence of choroidal neovascular membranes.
A recent review comparing OCT to FA in evaluating neovascular AMD determined that OCT had high sensitivity (85%) but low specificity (48%) in diagnosing and monitoring neovascular AMD,9 thus reinforcing FA as the gold standard for the management of this disease.
Further development of OCT angiography technologies, however, may change this perspective. Appropriate use of OCT requires the use of adjunctive imaging tools as needed to complete a thorough interpretation.
CONCLUSION
While OCT is a very useful tool and has revolutionized the field of ophthalmology since its inception, to utilize it to its maximum potential, a good understanding of the technology is as important as a strong grasp of retinal histology.
A systematic method of interpretation and an awareness of the possible errors, limitations, and artifacts generated are vital to the appropriate evaluation of the images acquired. RP
REFERENCES
1. Fercher AF, Mengedoht K, Werner W. Eye-length measurement by interferometry with partially coherent light. Opt Lett. 1988;13:186-188.
2. Huang D, Swanson EA, Lin CP, et al. Optical coherence tomography. Science. 1991;254:1178-1181.
3. Gabriele ML, Wollstein G, Ishikawa H, et al. Optical coherence tomography: history, current status, and laboratory work. Invest Ophthalmol Vis Sci. 2011;52:2425-2436.
4. Grewal DS, Tanna AP. Diagnosis of glaucoma and detection of glaucoma progression using spectral domain optical coherence tomography. Curr Opin Ophthalmol. 2013;24:150-161.
5. Nouri-Mahdavi K, Nowroozizadeh S, Nassiri N, et al. Macular ganglion cell/inner plexiform layer measurements by spectral domain optical coherence tomography for detection of early glaucoma and comparison to retinal nerve fiber layer measurements. Am J Ophthalmol. 2013;156:1297-1307.
6. Loewen NA, Zhang X, Tan O, et al. Combining measurements from three anatomical areas for glaucoma diagnosis using Fourier-domain optical coherence tomography. Br J Ophthalmol. 2015 Mar 20. [Epub ahead of print]
7. Dirani A, Gianniou C, Marchionno L, Decugis D, Mantel I. Incidence of outer retinal tubulation in ranibizumab-treated age-related macular degeneration. Retina. 2015 Jan 8. [Epub ahead of print]
8. Hariri A, Nittala MG, Sadda SR. Outer retinal tubulation as a predictor of the enlargement amount of geographic atrophy in age-related macular degeneration. Ophthalmology. 2015;122:407-413.
9. Castillo MM, Mowatt G, Elders A, et al. Optical coherence tomography for the monitoring of neovascular age-related macular degeneration: a systematic review. Ophthalmology. 2015;122:399-406.








